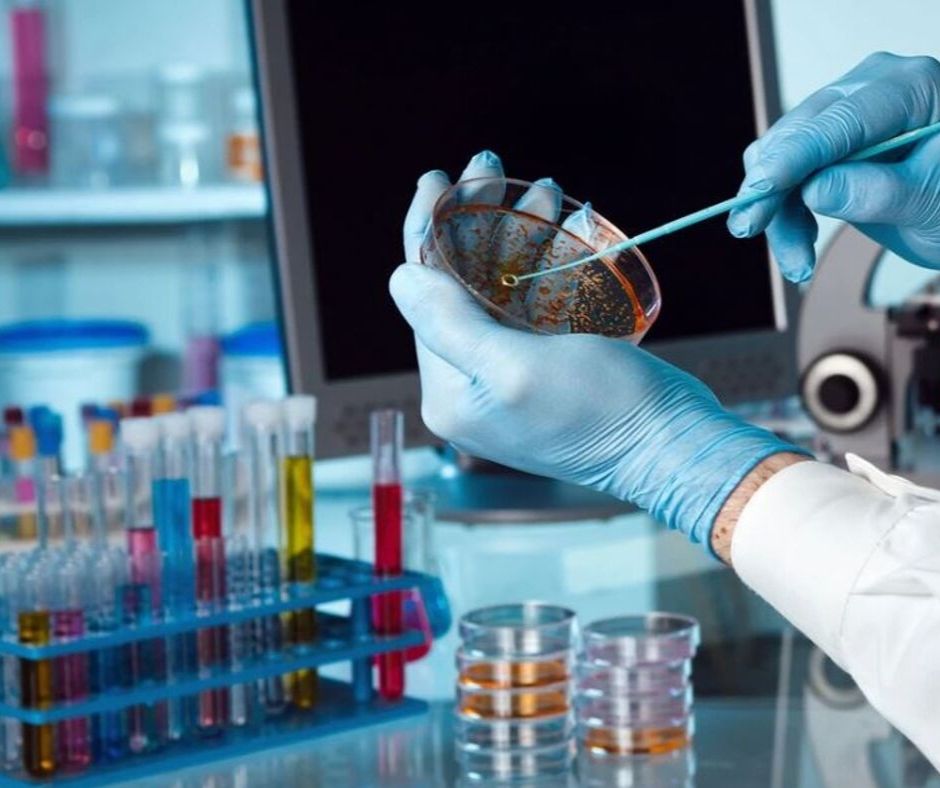

Dentro del lugar, habían muestras con viruela y ébola 💉🦠
Durante la noche de ayer, 17 de septiembre, la cadena británica de noticias de la BBC News, reportó una explosión que causó un incendio, en una instalación de investigaciones biológicas en Rusia.
“El incidente no representa un riesgo biológico ni de ningún otro tipo para la población local”

Mientras, se sabe que en este centro se encontraban muestras potenciales de viruela, ébola y hepatitis. Además, el Centro Estatal Ruso de Investigación de Virología y Biotecnología se incendió, porque un cilindro de gas, dentro de una zona en reparación, explotó.
Se informa que un trabajador resultó herido en el incidente y está recibiendo tratamiento para sus severas quemaduras. Por otra parte, las declaraciones hechas hasta el momento, reportan fuera de riesgo al centro y las zonas cercanas. Mientras, el alcalde de la ciudad dijo que el incidente no representa un riesgo biológico ni de ningún otro tipo para la población local.
Sin embargo, la explosión causó que las ventanas se rompieran, pero no hubo daño estructural, además, las muestras no representan ningún tipo de peligro, pues estaban en otra área del centro.
Aun así, la población y los medios se preguntan si los virus podrían sobrevivir a la explosión. Por lo que, en las declaraciones se dio a conocer que el acceso a las muestras es limitado, pues se utilizan contenedores especiales y el mecanismo de almacenamiento es diferente al de otros laboratorios.

Sin embargo, para tranquilizar a los pobladores, agregó que: “el fuego sería lo suficientemente caliente como para destruir virus”. Pese a esto, se sabe que una explosión podría correr el riesgo de propagar el virus y existiría el peligro de infectar a las personas en la habitación o contaminar el área inmediata más cercana.